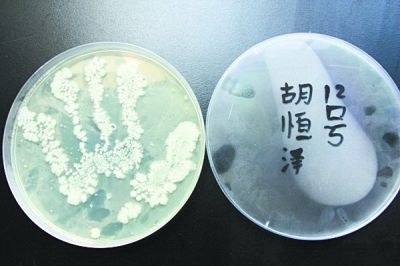
手上的细菌怎么如此多?
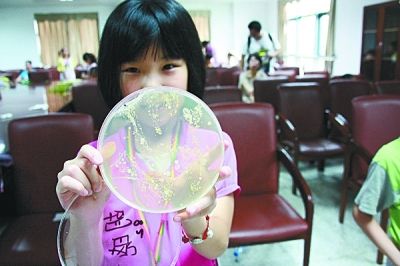
手上的细菌怎么如此多?_资讯频道_凤凰网

牵小孩时手上的细菌图片
1000x998 - 98KB - JPEG

人类可以捏死手上的细菌吗? 科学答案让人哭笑不得, 不信你试试!|细菌
972x492 - 203KB - PNG

人类可以捏死手上的细菌吗? 科学答案让人哭笑不得, 不信你试试!|细菌
677x377 - 159KB - PNG

你知道一个从外面撒完野回来的8岁小屁孩手上有多少细菌吗? - 正午 - 闪播网
640x580 - 217KB - JPEG

手上的细菌图片下载(图片ID:585387)_-医疗护理-图片素材
1000x951 - 155KB - JPEG
手上的细菌怎么如此多?
400x266 - 18KB - JPEG
手上的细菌怎么如此多?_资讯频道_凤凰网
400x266 - 22KB - JPEG

手掌上的细菌图片
999x1000 - 89KB - JPEG

手上的细菌病毒素材_病毒细菌_细菌病毒_图品汇
480x480 - 29KB - JPEG

图文:孩子的小手上有多少细菌?-搜狐滚动
570x516 - 92KB - JPEG

在人类手上的细菌
1023x718 - 257KB - JPEG

我用力一握拳,会捏死手上的细菌吗?
640x486 - 56KB - JPEG

矢量卡通小男孩手上放大的卡通细菌
800x500 - 57KB - JPEG

矢量卡通小男孩手上放大的卡通细菌
800x800 - 122KB - JPEG

放大镜观看的手上的蓝色细菌矢量图
449x336 - 98KB - JPEG